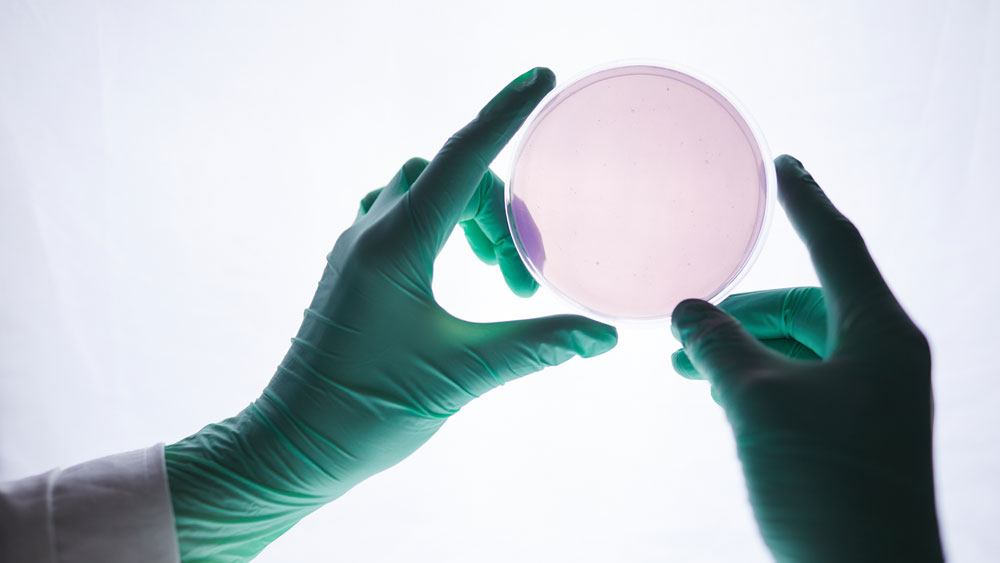
Laboratorio

Growth Entrepreneurship Programme published: medium-sized companies have significant leverage effect on national economy
The Growth Entrepreneurship Programme (incl. ‘Mittelstand’ companies) was published on 22.5.2025. The aim of the Growth Entrepreneurship Programme, which is based on the Government Programme, is to double the number of medium-sized companies and midcaps.
Although few in number, medium-sized companies have a significant leverage effect on the national economy – they are important employers and generate considerable value added. Achieving the objective also requires that an increasing number of small growth companies grow into medium-sized businesses.
Of the medium-sized companies about 80% are growth-oriented but there is much less actual growth, which means that all too often willingness to grow does not translate into growth. Growth-oriented medium-sized companies and midcaps need incentives to strengthen their growth capacity, which is also important to increase the number of export companies.
The means to boost growth presented in the programme include appropriate targeting of public business and financing services and measures to improve the operating environment. The challenges for growth are multidimensional and several mutually complementary actions are needed to address them. The Growth Entrepreneurship Programme contains 17 proposals for measures under five main themes:
- Support for the growth capacity, renewal and internationalisation of companies
- More focused targeting of financing for growth
- Improving the functioning of business service chains to boost the growth capacity, renewal and internationalisation of companies
- Responding to the skills and competence needs of growth companies
- Other measures
The programme also contains 12 indicators that will be used in monitoring the programme.
The programme was prepared by the working group on the Growth Entrepreneurship Programme of the Ministry of Economic Affairs and Employment composed of representatives of the relevant ministries and the administrative branch of the Ministry of Economic Affairs and Employment. Various other stakeholders participated in the expanded working group. The planning of the implementation of the programme has been started.
Inquiries:
Kari Virtanen, Senior Ministerial Adviser, Ministry of Economic Affairs and Employment, tel. +358 295 047 707
Jaana Lappi, Ministerial Adviser, Ministry of Economic Affairs and Employment, tel. +358 50 3088 143
TEM:n tiedote 11.4.2025: Kasvuyrittäjyyden ohjelmalle jatkoaskeleet